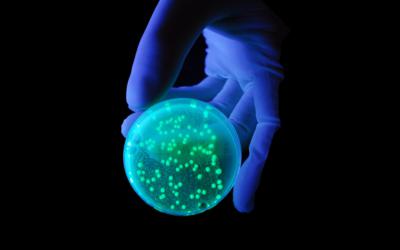
Биологическое действие ультрафиолета

Какая бактерицидная доза излучения требуется для бактерицидного эффекта?
Работа бактерицидных ламп характеризуется радиометрическими величинами. Основными из них являются бактерицидная доза и бактерицидная эффективность.

Работа бактерицидных ламп характеризуется радиометрическими величинами. Основными из них являются бактерицидная доза и бактерицидная эффективность.
Во время действия на живые организмы, УФ-излучения поглощается уже верхними слоями тканей, растений или кожи человека и животных.

Мережа супермаркетів "Велика Кишеня" запустила можливість оплати за допомогою FaceID на касах самообслуговування
Починаючит з листопада отримють можливість безкоштовно оновити свої ID-картки, додавши електронний підпис